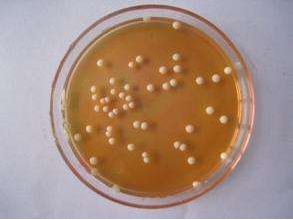

培养基制备的操作要点合集
制作培养基真真是微生物实验室的家常便饭,培养基配成后一般需测试并调节pH,还须进行灭菌,培养基由于富含营养物质,易被污染或变质,配制过程中有多个注意事项和操作要点需要我们掌握,接下来就一起看看吧。
首先,什么是培养基?
培养基,是指供给微生物、植物或动物(或组织)生长繁殖的,由不同营养物质组合配制而成的营养基质。一般都含有碳水化合物、含氮物质、无机盐(包括微量元素)、维生素和水等几大类物质。培养基既是提供细胞营养和促使细胞增殖的基础物质,也是细胞生长和繁殖的生存环境。
其次,培养基的种类。
培养基种类很多,根据配制原料的来源可分为自然培养基、合成培养基、半合成培养基;根据物理状态可分为固体培养基、液体培养基、半固体培养基;根据培养功能可分为基础培养基、选择培养基、加富培养基、鉴别培养基等;根据使用范围可分为细菌培养基、放线菌培养基、酵母菌培养基、真菌培养基等。
最后,培养基配制须知。
培养基配成后一般需测试并调节pH,还须进行灭菌,通常有高温灭菌和过滤灭菌。培养基由于富含营养物质,易被污染或变质。配好后不宜久置,最好现配现用。
玻璃器皿的清洗
在制备培养基的过程中,首先要使用一些玻璃器皿,如试管、三角瓶、培养皿、烧杯和吸管等。这些器皿在使用前都要根据不同的情况,经过一定的处理,洗刷干净。有的还要进行包装,经过灭菌等准备就绪后,才能使用。
1、新购的玻璃器皿
除去包装沾染的污垢后,先用热肥皂水刷洗,流水冲净,再浸泡于1~2%的工业盐酸中数小时,使游离的碱性物质除去,再以流水冲净。对容量较大的器皿,如大烧瓶、量筒等,洗净后注入浓盐酸少许,转动容器使其内部表面均沾有盐酸,数分钟后倾去盐酸,再以流水冲净,倒置于洗涤架上将水空干,即可使用。
2、用过的玻璃器皿
凡确无病原菌或未被带菌物污染的器皿,使用后可随时冲洗,吸取过化学试剂的吸管,可先浸泡于清水中,待到一定数量后再集中进行清洗。有可能被病原菌污染的器皿,必须经过适当消毒后,将污垢除去,用皂液洗刷,再用流水冲洗干净。若用皂液未能洗净的器皿,可用洗液浸泡适当时间后再用清水洗净。洗液的主要成份是重铬-酸钾和浓流酸,其作用是将有机物氧化成可溶性物质,以便冲洗。洗液有很强的腐蚀作用,使用时应特别小心,避免溅到衣服、身体和其他物品上。
培养基制备的基本方法和注意事项
1、培养基配方的选定
同一种培养基的配方在不同着作中常会有某些差别。因此,除所用的是标准方法,应严格按其规定进行配制外,一般均应尽量收集有关资料,加以比较核对,再依据自己的使用目的,加以选用,记录其来源。
2、培养基的制备记录
每次制备培养基均应有记录,包括培养基名称,配方及其来源,和各种成份的牌号,最终pH值、消毒的温度和时间制备的日期和制备者等,记录应复制一份,原记录保存备查,复制记录随制好的培养基一同存放、以防发生混乱。
3、培养基成分的称取
培养基的各种成分必须精确称取并要注意防止错乱,最好一次完成,不要中断。可将配方置于傍侧,每称完一种成分即在配方面军做出记号,并将所需称取的药品一次取齐,置于左侧,每种称取完毕后,即移放于右侧。完全称取完毕后,还应进行一次检查。
4、培养基各成份的混合和溶化
培养基所用化学药品均应是化学纯的。使用的蒸煮锅不得为铜锅或铁锅,以防有微量铜或铁混入培养基中,使细菌不易生长。最好使用不锈钢锅加热溶化,可放入大烧杯或大烧瓶中置高压蒸汽灭菌器或流动蒸汽消毒器中蒸煮溶化。在锅中溶化时、可先用温水加热并随时扰动、以防焦化、如发现有焦化现象、该培养基即不能使用,应重新制备。待大部分固体成分溶化后,再用较小火力使所有成分完全溶化,迄至煮沸。如为琼脂溶化,用另一部分水溶化其它成分,然后将两溶液充分混合。在加热溶化过程中,因蒸发而丢失的水分,最后必须加以补足。
5、培养基pH的初步调正
因培养基在加热消毒过程中、pH会有所变化,培养基各成分完全溶解后,应进行PH的初步调正。例如,牛肉浸液约可降低pH0.2,而肠浸液pH却会有显着的升高。因此,对这个步骤,操作者应随时注意探索经验、以期能掌握培养基的最终PH,保证培养基的质量。PH调整后,还应将培养基煮沸数分钟,以利培养基沉淀物的析出。
6、培养基的过滤澄清
液体培养基必须绝对澄清,琼脂培养基也应透明无显着沉淀,因此,须要采用过滤或其它澄清方法以达到此项要求。一般液体培养基可用滤纸过滤法,滤纸应折叠成折扇或漏斗形,以避免因液压不均匀而引起滤纸破裂。
琼脂培养基可用清洁的白色薄绒布趁热过滤。亦可用中间夹有薄层吸水棉的双层纱布过滤。新制肉、肝、血和土豆等浸液时、则须先用绒布将碎渣滤去,再用滤纸反复过滤。如过滤法不能达到澄清要求、则须用蛋清澄清法。即将冷却至55~60°C的培养基放入大的三角烧瓶内,装入量不得超过烧瓶容量的1/2,每1000ml培养基加入1~2个鸡蛋的蛋白,强力振摇3~5分钟,置高压蒸汽灭菌器中、121°C加热20分钟、取出趁热以绒布过滤即可。
7、培养基的分装
培养基的分装,应按使用的目的和要求,分装于试管、烧瓶等适当容器内。分装量不得超容器装盛量的2/3。容器口可用垫有防湿纸的棉塞封堵,其外还须用防水纸包扎(现试管一般多有用螺旋盖者)。分装时最好能使用半自动或电动的定量分装器。分装琼脂斜面培养基时,分装量应以能形成2/3底层和1/3斜面的量为洽当。分装容器应预先清洗干净并经干烤消毒,以利于培养基的彻底灭菌。每批培养基应另外分装20ml培养基于一小玻璃瓶中,随该批培养基同时灭菌,以为测定该批培养基最终pH之用。
8、培养基的灭菌
一般培养基可采用121°C高压蒸汽灭菌15分钟的方法。在各种培养基制备方法中,如无特殊规定,即可用此法灭菌。
某些畏热成分,如糖类,应另行配成20%或更高的浓液,以过滤或间歇灭菌法消毒,以后再用无菌操作技术、定量加于培养基。明胶培养基亦应用较低温度灭菌。血液、体液和抗生素等则应以无菌操作技术抽取和加入于经冷却约50°C左右的培养基中。
琼脂斜面培养基应在灭菌后立即取出,冷至55℃-60℃时,摆置成适当斜面,待其自然凝固。
9、培养基的质量测试
每批培养基制备好以后,应仔细检查一遍,如发现破裂、水分浸入、色泽异常、棉塞被培养基沾染等、均应挑出弃去。并测定其最终pH。
将全部培养基放入36±1°C恒温箱培养过夜,如发现有菌生长,即弃去。
用有关的标准菌株接种1~2管或瓶培养基,培养24~48小时,如无菌生长或生长不好。应追查原因并重复接种一次,如结果仍同前,则该批培养基即应弃去,不能使用。
10、培养基的保存
培养基应存放于冷暗处,最好能放于普通冰箱内。放置时间不宜超过一周,倾注的平板培养基不宜超过3天。每批培养基均必须附有该批培养基制备记录副页或明显标签。
来源:上海远慕生物科技有限公司

